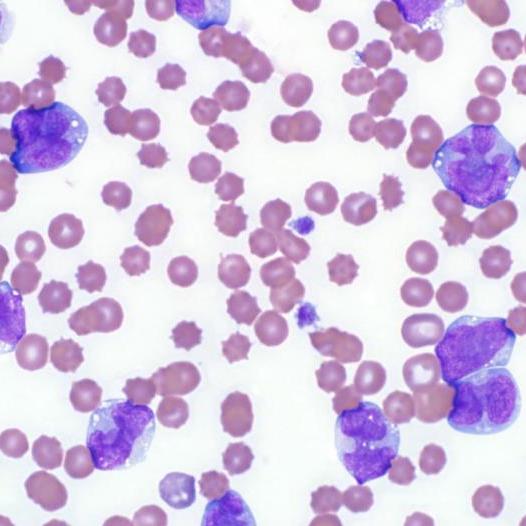
Feline leukemia virus (FeLV)

Male Vc. Female
Which one should I choose Male or Female?
The decision to adopt a male or female cat depends on your personal preferences and what you're looking for in a feline companion. Both male and female cats can make wonderful and loving pets, so it's important to consider factors that align with your lifestyle and preferences. Here are some things to consider when deciding whether to adopt a male or female cat:
Lap Breed
Are the Scottish Fold/Straight lap cats?
Yes, Scottish Fold/Straight cats are often considered lap cats due to their affectionate and gentle nature. While individual personalities can vary, many Scottish Folds/Straights enjoy sitting on their owner's lap, cuddling, and being close to their human companions. Their sweet and sociable disposition makes them well-suited for forming strong bonds with their owners and being part of family activities.
20 Facts About Scottish Fold
Certainly! Here are 20 interesting facts about the Scottish Fold breed:
Genetic of Scottish cats
Breeding Scottish Fold/Straight cats can lead to specific genetic health concerns due to the gene responsible for their distinctive folded ears. The same gene can affect the development of cartilage throughout the body, leading to potential skeletal and joint issues. Here are some of the genetic problems associated with breeding Scottish Fold cats:
Straight vc. Fold
"Straights" and "Folds" are terms used to describe the two types of ears found in the Scottish Fold cat breed.
Straights: "Straights" refer to Scottish Fold kittens and cats that have traditional, upright ears that stand straight up like those of most other cat breeds. These cats do not carry the genetic mutation that causes the characteristic folded ears of the Scottish Fold breed.
Hypoallergenic
Scottish Folds/Straights are not considered hypoallergenic. Hypoallergenic Scottish folds/straights are those that produce fewer allergens than other cats, which can be beneficial for people with allergies. However, the presence of allergens varies not only between breeds but also among individual cats within the same breed.
Grooming
Grooming your Scottish Fold/Straight cat/kitten, whether it has long or short hair, is important for maintaining a healthy coat, preventing matting, and building a strong bond with your pet. Here's a guide on how to properly groom your Scottish Fold/Straight kitten based on its coat type:
Shedding
Scottish Fold/Straight cats/kittens, like many other breeds, do shed their fur, but the amount of shedding can vary from cat to cat. The shedding level of a Scottish Fold/Straight kitten or cat depends on factors such as genetics, coat type, and individual variations.
Scottish Folds/Straights can have either short or long coats. Short-haired Scottish Folds have a dense, plush coat, while long-haired Scottish Folds/Straights have a softer, longer coat. Both coat types will shed.
Children & Pet Friendly
When introducing a Scottish Fold/Straight to children:
Scottish Folds/Straights are generally known to be good with children and other pets. Their sweet and gentle nature and social disposition often make them well-suited for households with kids and other animals. However, as with any breed, individual personalities can vary, so it's important to introduce any new pet to your family slowly and under supervision.
Personality & Temperament
The Scottish Fold/Straight is a distinctive breed of cat known for its unique folded ears and charming appearance. Regarding personality and temperament, Scottish Folds/Straight are generally known for their sweet and gentle nature. However, it's important to remember that individual cats within a breed can vary in terms of their personalities. Here are some common characteristics associated with the Scottish Fold/Straight breed:
The history of the Scottish Fold
The history of the Scottish Fold breed is a fascinating journey that began with a chance discovery on a farm in Scotland. Here's an expanded overview of the breed's history:
Feline leukemia virus (FeLV)
Feline Leukemia Virus (FeLV) is second only to trauma as the leading cause of death in cats, killing 85% of persistently infected felines within three years of diagnosis. The virus commonly causes anemia or lymphoma, but because it suppresses the immune system, it can also predispose cats to deadly infections.
Feline immunodeficiency virus (FIV)
In infected cats, Feline Immunodeficiency Virus (FIV) attacks the immune system, leaving the cat vulnerable to many other infections. Although cats infected with FIV may appear normal for years, they eventually suffer from this immune deficiency, which allows normally harmless bacteria, viruses, protozoa, and fungi found in the everyday environment to potentially cause severe illnesses. The median survival time for a cat diagnosed with FIV is approximately five years.
Feline Coronavirus (FCoV)
What are Coronavirus?
Coronavirus is most often found in young cats or multi-cat households where it is spread through feces and airborne contaminants. Fatalities most often occur in cats who are young or have a weakened immune system. Coronavirus in cats, or Feline Infectious Peritonitis, is a viral disease caused by certain strains of feline Coronavirus. Though most strains of feline Coronavirus do not cause the disease to occur, some strains can cause symptoms that range from mild to severe. These strains may also mutate in the cat's body, becoming Feline Infectious Peritonitis Virus (FIPV). This virus attacks the immune system and vital organs, resulting in the death of the cat.
Feline Infectious Peritonitis (FIPV)
What is Feline Infectious Peritonitis (FIP)?
Feline Infectious Peritonitis (FIP) is a fatal viral disease caused by a strain of virus called Feline Coronavirus (FCoV). Many cats carry this worldwide virus. FIP is much more prevalent in multi-cat households, shelters, and breeding colonies. Most cats carry the Feline Enteric Coronavirus (FECV) which, rarely causes disease in itself. When the feline Coronavirus mutates into a strain of the virus that has the ability to cause disease it is referred to as the FIP virus. It is fortunate that the mutation only occurs rarely.
Food for Scottish Fold / Stright Cats
Nutritional Recommendations for Scottish Fold / Stright Cats and kittens.
Proper nutrition is essential for your furry pet to maintain good health and a beautiful appearance. The easiest way to feed you cat is to purchase premium commercial cat food. However, those who are willing to spend more time and effort taking care of their cats may choose a more complicated and expensive, yet more healthy, way to feed their animals by creating a menu based on natural products. A cat is a predator; therefore, its nutrition should consist mainly of meat.
However, the opinions of feline owners differ on which meat to use and how it should be prepared. Some give their cats raw meat, some boil it and some cook it in a microwave. So, which is best?
Spay / Neuter Your Pet
By spaying or neutering your pet, you’ll help control the pet homelessness crisis, which results in millions of healthy dogs and cats being euthanized in the United States each year simply because there aren’t enough homes to go around. There are also medical and behavioral benefits to spaying (female pets) and neutering (male pets) your animals.
Our cattery
Contact us
Royal Purebred Kittens, LLC
DBA: Royal Bengal Cattery • Royal Maine Coon Cattery • Royal Scottish Fold Cattery